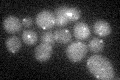
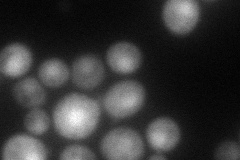
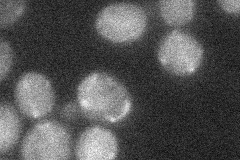
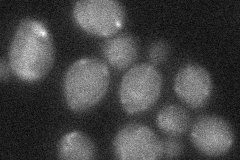
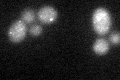
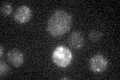

View description
Mitochondrial outer membrane protein, required for transmission of mitochondria to daughter cells; component of the ERMES complex that links the ER to mitochondria; may influence import and assembly of outer membrane beta-barrel proteins
Localization:
Intensity:
Fold change:
Significance:
-
C’ GFP library in SD
punctate16.48 -
N' NOP1pr-GFP in SD

cytosol,punctate51.1581 -
N' TEF2pr-mCherry in SD
cytosol,nucleus79.7558 -
N' NATIVEpr-GFP in SD
punctate22.9826 -
N' TEF2pr-VC and Cyto-VN in SD
below threshold25.03 -
C’ GFP library in SD+DTT
punctate15.930.96No -
C’ GFP library in SD+H2O2

punctate14.270.86No -
C’ GFP library in Starvation Media
punctate18.961.15No -
C’ GFP library on the background of Pup2-DaMP

punctate -
C’ GFP library on the background of CCT mutant

punctate14.57190.883797No
